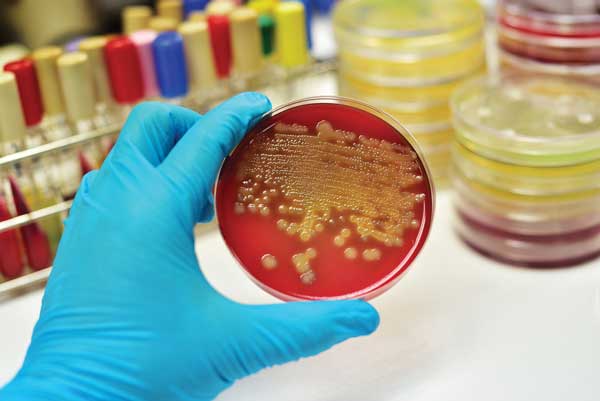
Microbial modeling is used to study the growth or survival of microorganisms over a period under specified conditions.

Microbial Modeling Predicts Shelf Life and Safety
FOOD SAFETY AND QUALITY
Microbial modeling is not a microorganism walking down a runway like a fashion model but rather a method of predicting the shelf life and safety of food formulation options. It is being increasingly used by food companies and regulatory agencies to develop products and processes, set performance standards, evaluate regulatory compliance, and assess risk. In microbial modeling, mathematical models are used to predict the growth or survival of microorganisms in foods. The models are developed by s…
Microbial modeling is not a microorganism walking down a runway like a fashion model but rather a method of predicting the shelf life and safety of food formulation options. It is being increasingly used by food companies and regulatory agencies to develop products and processes, set performance standards, evaluate regulatory compliance, and assess risk. In microbial modeling, mathematical models are used to predict the growth or survival of microorganisms in foods. The models are developed by s…
Top


